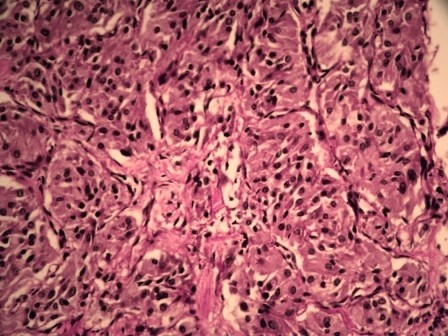
Figure 6

Figure 6
From: Pentalogy of Fallot and cardiac paraganglioma: a case report

Photomicrograph showing nests of polygonal cells with eosinophilic cytoplasm and round regular nuclei with fine chromatin (H&E, 400×).
From: Pentalogy of Fallot and cardiac paraganglioma: a case report
Photomicrograph showing nests of polygonal cells with eosinophilic cytoplasm and round regular nuclei with fine chromatin (H&E, 400×).